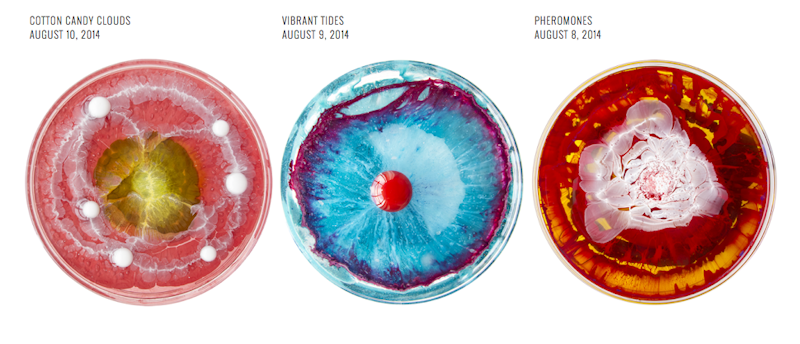

A Daily Dish
Klari Reis paints a new petri dish everyday. "The paintings are created using reflective epoxy polymer and are an attempt to explore our complex relationship with today’s biotechnological industry." Via VSL.

Klari Reis paints a new petri dish everyday. "The paintings are created using reflective epoxy polymer and are an attempt to explore our complex relationship with today’s biotechnological industry." Via VSL.